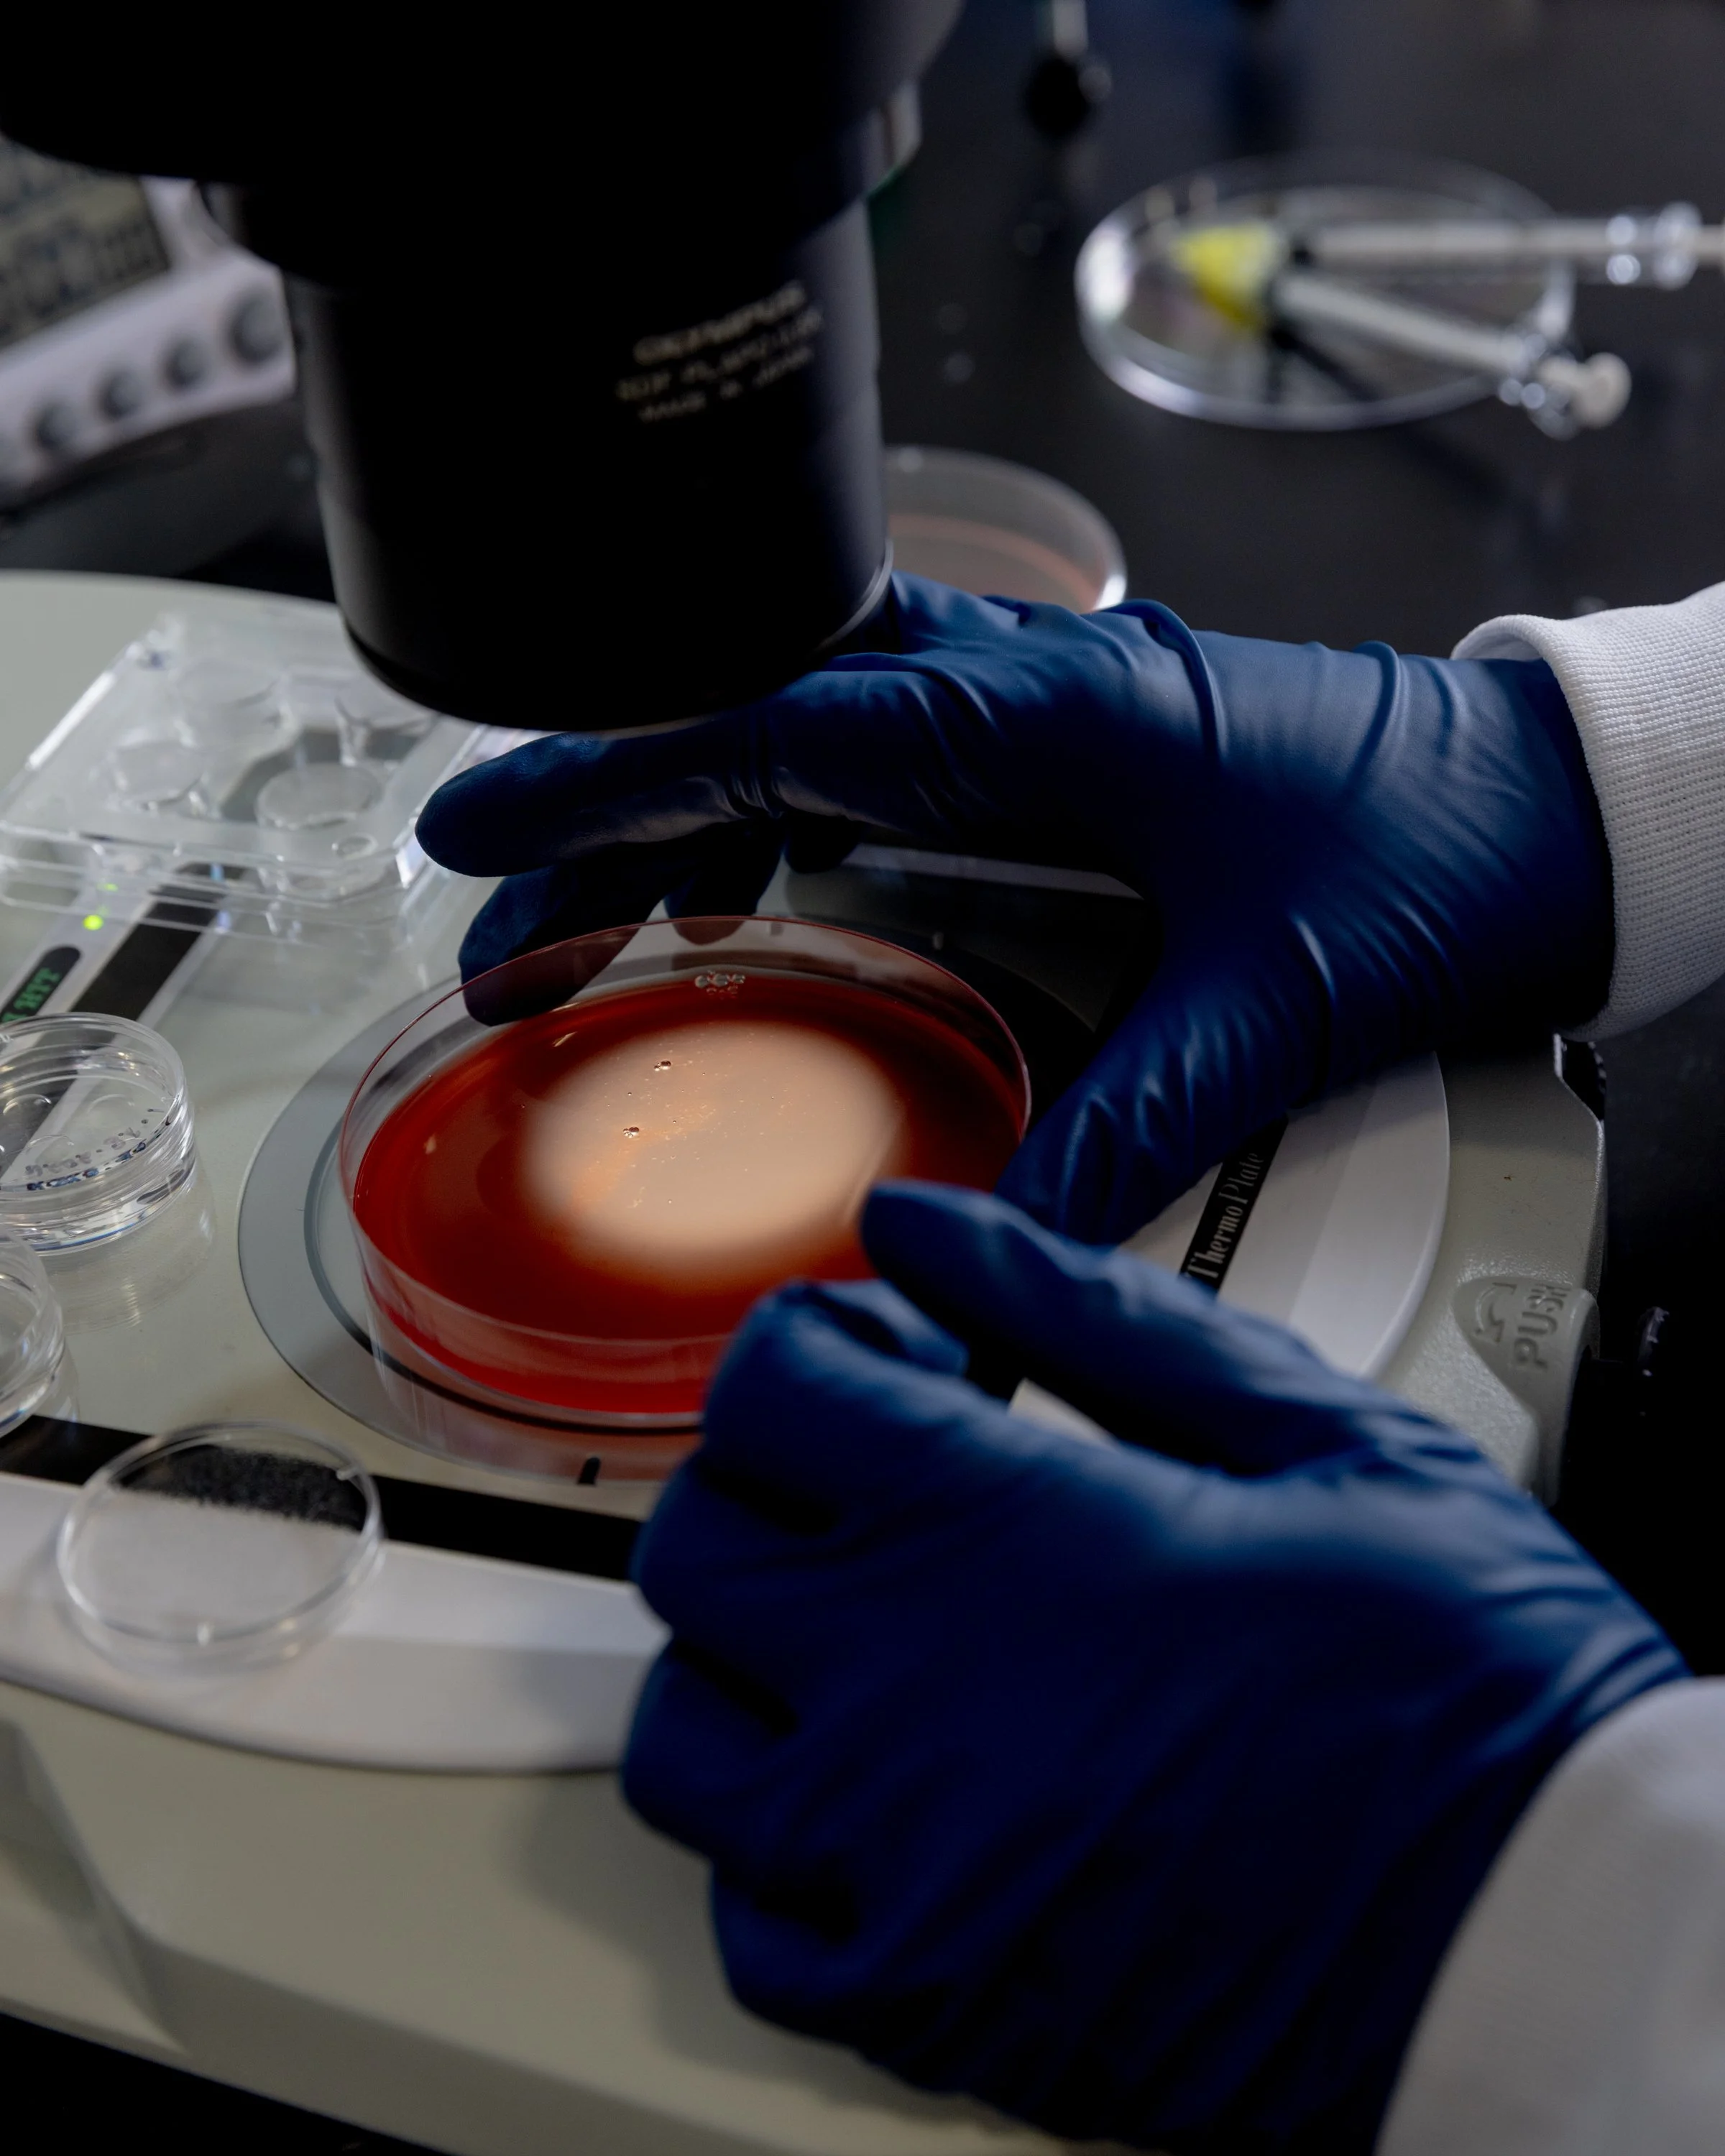
New Method to Aid in Fertility Treatment   The New York Times

NASA's Artemis II Mission
The New York Times
New Method to Aid in Fertility Treatment
The New York Times
AI's Most Promising Alien Hunters
Bloomberg Businessweek
The Earthling’s Guide to Building a Moon Base
The Economist
Why Cranberry Country is Turning into Wetlands
The Washington Post

The Great American Eclipse
The New York Times
Oyster Farms Divide Two New England Towns
The Wall Street Journal
Tiny Forests with Big Benefits
The New York Times / SUGi
There's No Place Like Mars
Smithsonian Magazine
Ash Trees are Vanishing, So Are the Basketmakers that Depend on Them
The New York Times
Launching of NASA's InSight Lander
National Geographic
Composer Deals in Drama and Dialogue
The New York Times